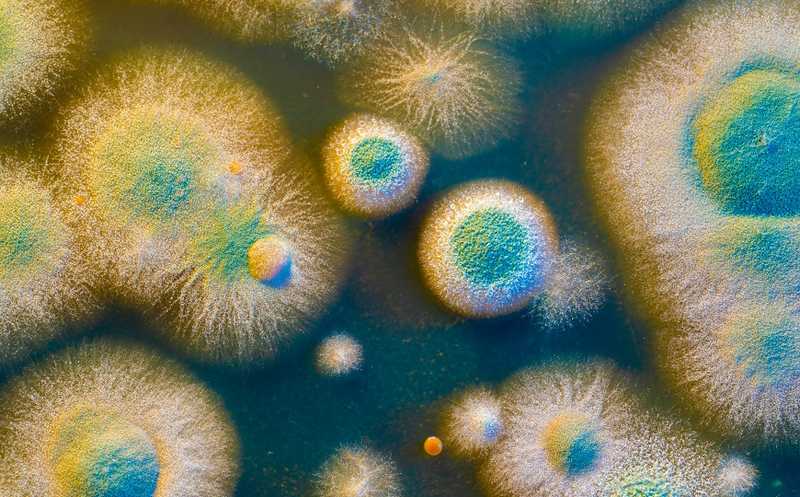

Новое противогрибковое средство выделили из патогена картофеля
Ранее из картофельного патогена — бактерии Dickeya solani — уже выделяли антибиотик ооцидин A. Но мутанты без ооцидина не теряли противогрибковой активности. Исследователи из Великобритании показали, что причина в другом антибиотике — соланимицине. Бактерия синтезирует его при повышении плотности клеток и при подкислении среды. Авторы показали противогрибковую активность соланимицина на важных сельскохозяйственных патогенах и дрожжах Candida albicans.
Ежегодно сельское хозяйство несет огромные потери из-за патогенов растений, прежде всего патогенных грибов. При этом грибы быстро вырабатывают резистентность к используемым в настоящее время фунгицидам. Существует необходимость в поиске новых веществ, активных против грибковых патогенов растений, животных и человека. Часто источником таких соединений становятся другие микроорганизмы. Исследователи из Великобритании выделили новое противогрибковое вещество — соланимицин — из энтеробактерии Dickeya solani, картофельного патогена.
Та же группа ученых ранее уже занималась D. solani. Эта бактерия несет несколько генных кластеров, кодирующих вторичные метаболиты, часть из которых уникальна для представителей этого рода. Одно из кодируемых ею противогрибковых соединений — ооцидин A. В ходе изучения D. solani авторы выявили несколько мутантов, которые не производили ооцидин A, но при этом не теряли противогрибковой активности. Они предположили, что бактерия производит еще какой-то антибиотик.
На основе одного их таких мутантов авторы получили новые мутантные штаммы D. solani, которые не обладали противогрибковой активностью вовсе или обладали, но очень слабой. С их помощью ученые идентифичировали генный кластер, который был нужен для выработки неизвестного ранее противогрибкового соединения, названного соланимицином. Кластер состоял из 12 открытых рамок считывания, с помощью анализа in silico авторы предположили, какую роль они играют в биосинтезе.
Проанализировав геномы 382 видов Dickeya spp., ученые показали, что подобные кластеры есть у чуть более чем ста из них. Также гены биосинтеза соланимицина выявили у других организмов, таких как в Pantoea sp. штамм A4, Erwinia species штаммы ErVv1 и AG740, Rouxiella chamberiensis 130333, Rouxiella badensis DSM 100043 и частично — в гамма-протеобактрии WG36 и Teredinibacter turnerae T7901. Есть свидетельства того, что бактерии приобрели этот кластер в результате горизонтального переноса генов. У различных бактерий кластеры имели разную организацию. Авторы подробно изучили строение кластера и определили, какие гены необходимы для биосинтеза соланимицина.
Анализ показал, что D. solani не всегда вырабатывает соланимицин. Так, его выработку вызывает повышение плотности клеток, а также подкисление среды — именно с этим стрессом сталкивается бактерия на начальных стадиях заражения растения. Авторы предполагают, что с помощью соланимицина D. solani избавляются от конкурентов после попадания в картофель.
Ученые выяснили, насколько эффективен соланимицин против 26 грибов — патогенов растений, относящихся к актиномикотам и базидиомикотам (включая Botrytis cinerea, Colletotrichum coccodes, Fusarium solani, Rhizoctonia solani и Verticillium dahliae). Соланимицин был эффективен в отношении 70% всех грибов, включая виды, важные для сельского хозяйства. Также была показана его активность в отношении дрожжей Candida albicans, Saccharomyces cerevisiae и Schizosaccharomyces pombe. Антибактериального действия у соланимицина выявлено не было.
Авторы совместно с химиками планируют изучить строение соланимицина, чтобы лучше понять, как тот работает, а затем проверить его на растительных и животных моделях. Их цель — использовать новое противогрибковое средство для защиты культурных растений.
Источник:
Miguel A. Matilla, et al. Solanimycin: Biosynthesis and Distribution of a New Antifungal Antibiotic Regulated by Two Quorum-Sensing Systems // mBio (2022), published October 10, 2022, DOI: 10.1128/mbio.02472-22


 Меню
Меню





 Все темы
Все темы




 0
0












